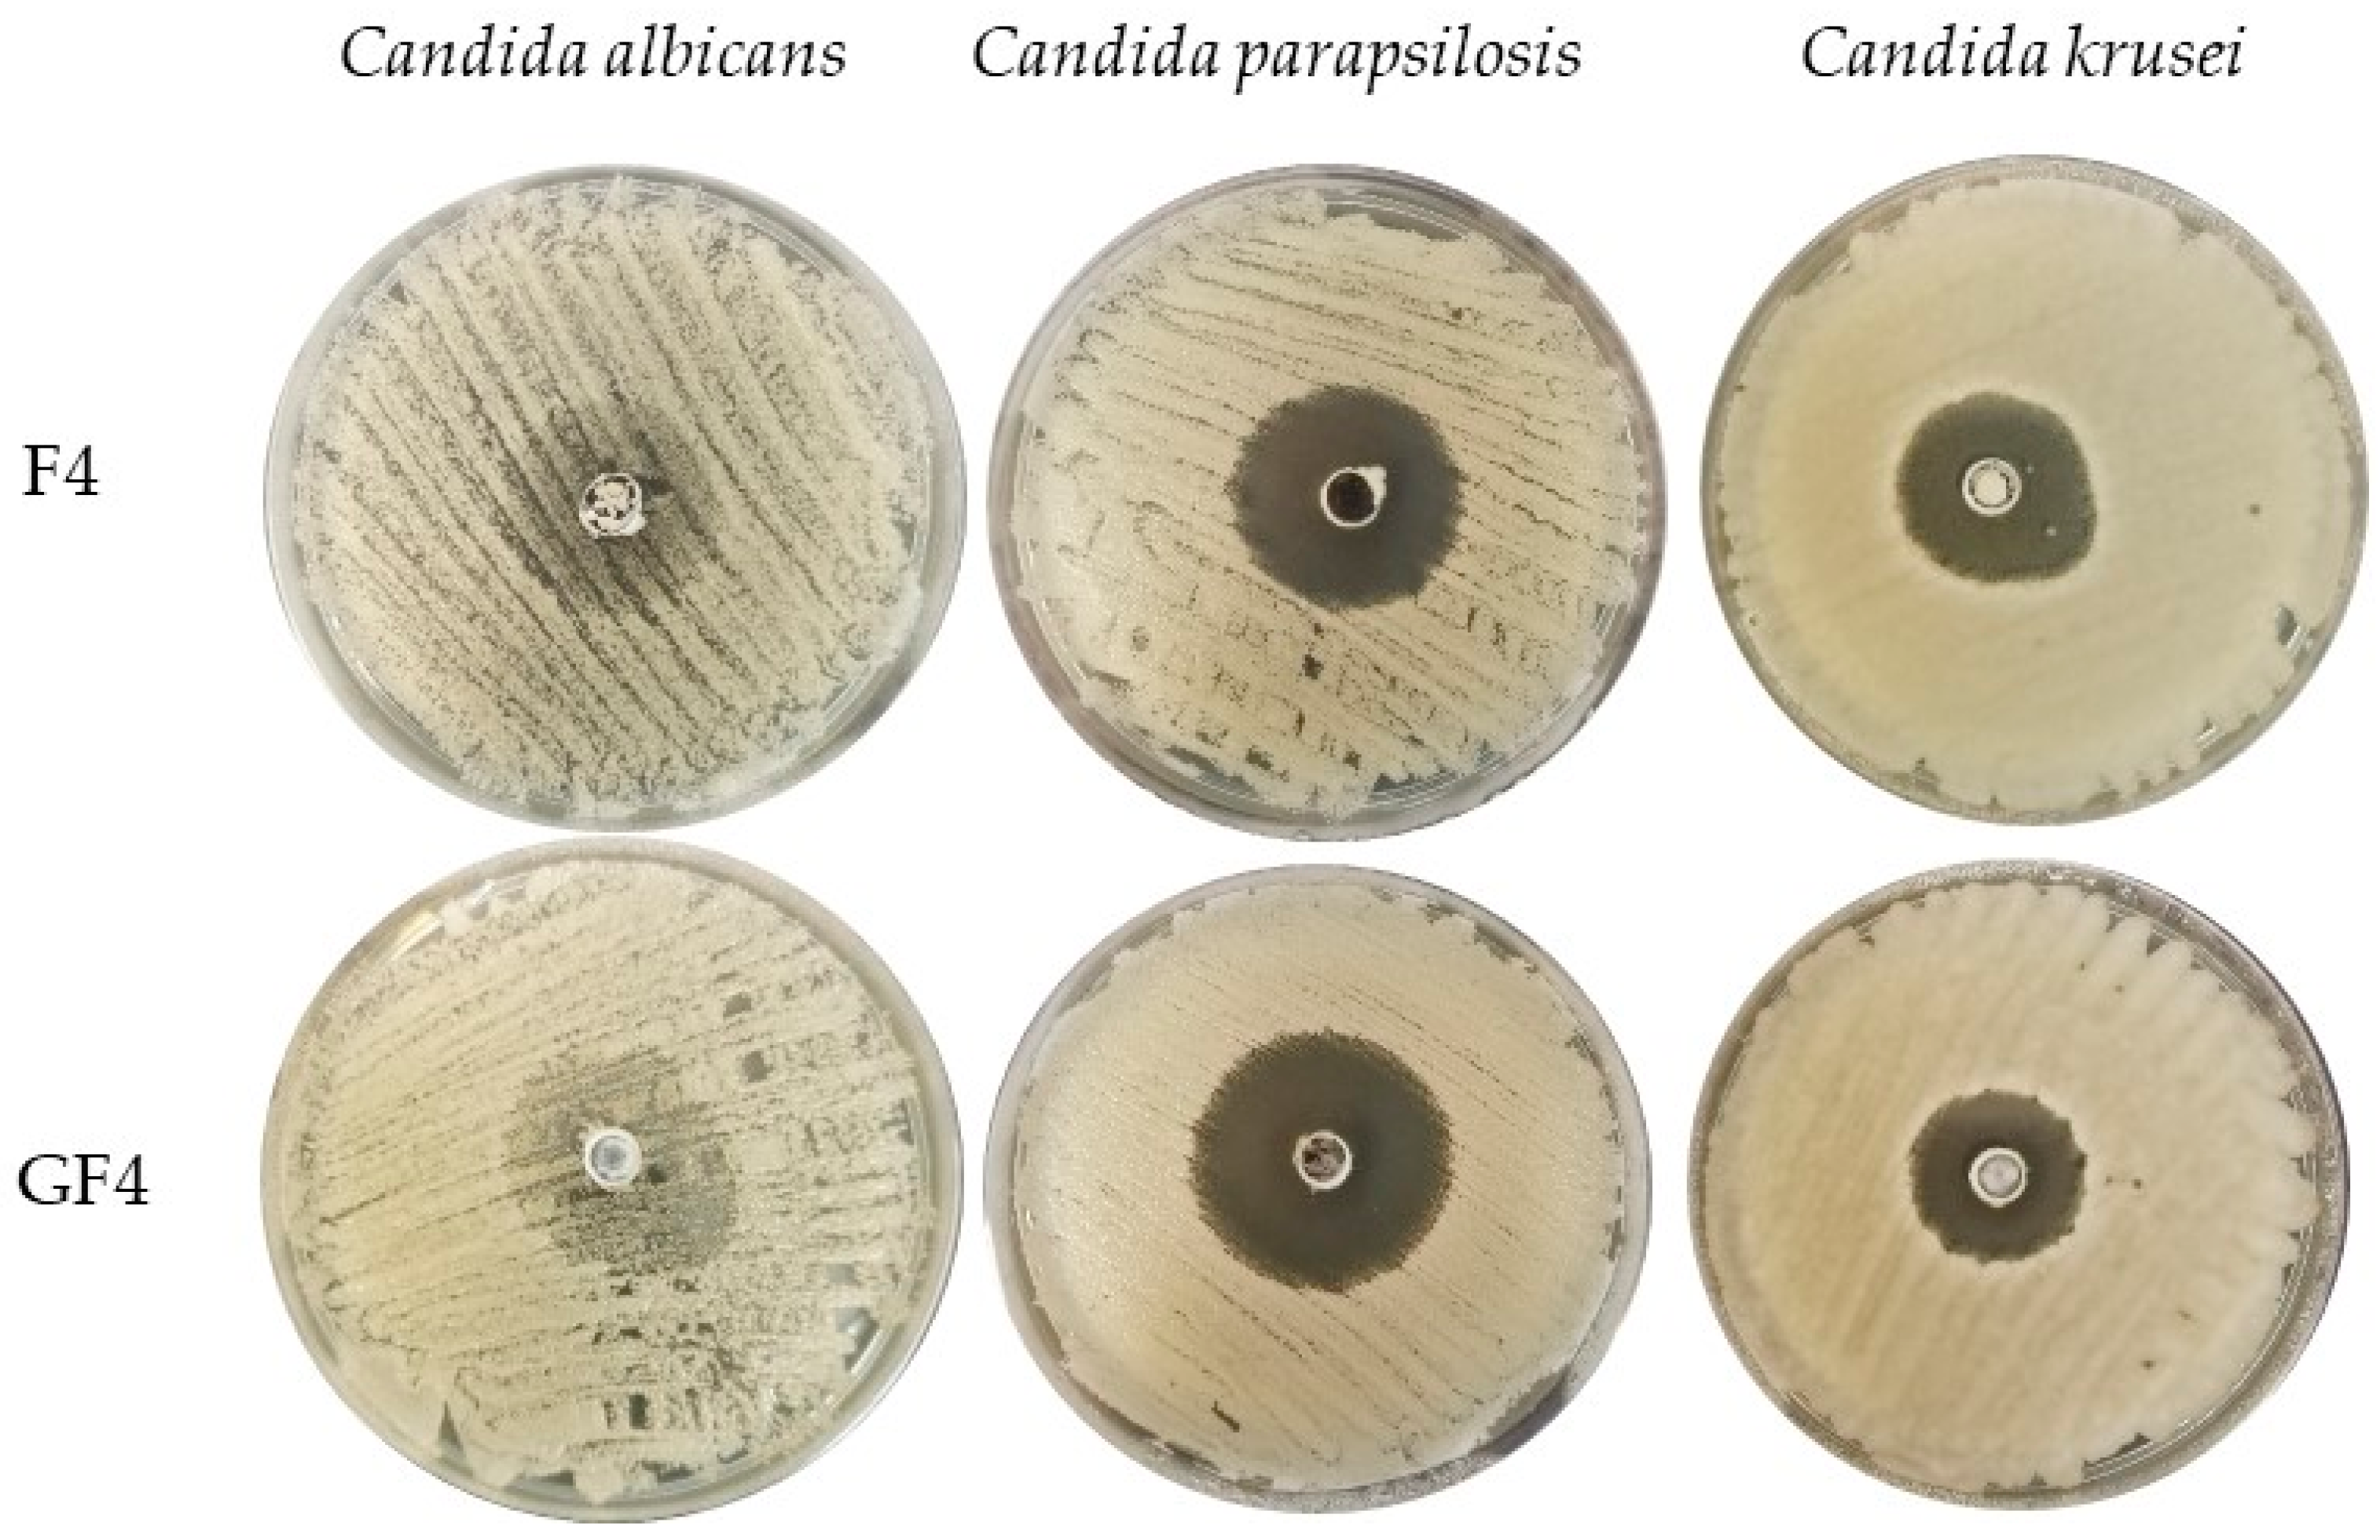
Materials 14 04087 g007

The Impact of Gelatin on the Pharmaceutical Characteristics of Fucoidan Microspheres with Posaconazole
Abstract
:1. Introduction
2. Materials and Methods
2.1. Materials
2.2. Preparation of Microparticles
2.3. Shape and Size
2.4. Evaluation of POS Loading, Encapsulation Efficiency and Production Yield
2.5. Swelling Properties
2.6. Mucoadhesive Properties
2.7. In Vitro POS Release
2.8. Mathematical Modeling of the POS Release Profile
2.9. Differential Scanning Calorimetry (DSC)
2.10. Antifungal Activity
2.11. Statistics
3. Results and Discussion
3.1. Microparticles Characteristics
3.2. Swelling and Mucoadhesion Ability
3.3. In Vitro POS Release
3.4. Differential Scanning Calorimetry (DSC)
3.5. Antifungal Activity
4. Conclusions
Author Contributions
Funding
Institutional Review Board Statement
Informed Consent Statement
Data Availability Statement
Acknowledgments
Conflicts of Interest
References
- von Lilienfeld-Toal, M.; Wagener, J.; Einsele, H.; Cornely, O.A.; Kurzai, O. Invasive fungal infection. Dtsch. Arztebl. Int. 2019, 116, 271–278. [Google Scholar] [CrossRef]
- Janbon, G.; Quintin, J.; Lanternier, F.; d’Enfert, C. Studying fungal pathogens of humans and fungal infections: Fungal diversity and diversity of approaches. Genes Immun. 2019, 20, 403–414. [Google Scholar] [CrossRef]
- Friedman, D.Z.P.; Schwartz, I.S. Emerging fungal infections: New patients, new patterns, and new pathogens. J. Fungi 2019, 20, 67. [Google Scholar] [CrossRef] [Green Version]
- Li, B.; Lu, F.; Wei, X.; Zhao, R. Fucoidan: Structure and bioactivity. Molecules 2008, 13, 1671–1695. [Google Scholar] [CrossRef] [PubMed] [Green Version]
- Wang, Y.; Xing, M.; Cao, Q.; Ji, A.; Liang, H.; Song, S. Biological activities of fucoidan and the factors mediating its therapeutic effects: A review of recent studies. Mar. Drugs 2019, 17, 183. [Google Scholar] [CrossRef] [PubMed] [Green Version]
- Luthuli, S.; Wu, S.; Cheng, Y.; Zheng, X.; Wu, M.; Tong, H. Therapeutic effects of fucoidan: A review on recent studies. Mar. Drugs 2019, 17, 487. [Google Scholar] [CrossRef] [PubMed] [Green Version]
- Marudhupandi, T.; Kumar, T. Antibacterial effect of fucoidan from Sargassum wightii against the chosen human bacterial pathogens. Int. Curr. Pharm. J. 2013, 2, 156–158. [Google Scholar] [CrossRef] [Green Version]
- van Weelden, G.; Bobiński, M.; Okła, K.; van Weelden, W.J.; Romano, A.; Pijnenborg, J.M.A. Fucoidan structure and activity in relation to anti-cancer mechanisms. Mar. Drugs 2019, 17, 32. [Google Scholar] [CrossRef] [Green Version]
- Abdul-Rehman, P.; Akhtar, A.; Madiha, A.; Muhammad, Z.; Ihsanul, H.; Song, J.K. In vitro antileishmanial, antibacterial, antifungal and anticancer activity of fucoidan from Undaria pinnatifida. Int. J. Biosci. 2017, 11, 219–227. [Google Scholar] [CrossRef]
- Etman, S.M.; Elnaggar, Y.S.R.; Abdallah, O.Y. Fucoidan, a natural biopolymer in cancer combating: From edible algae to nanocarrier tailoring. Int. J. Biol. Macromol. 2020, 15, 799–808. [Google Scholar] [CrossRef]
- Pérez, M.J.; Falqué, E.; Domínguez, H. Antimicrobial action of compounds from marine seaweed. Mar. Drugs. 2016, 14, 52. [Google Scholar] [CrossRef] [Green Version]
- FDA U.S. Food and Drug Administration. Available online: https://www.fda.gov/downloads/Food/IngredientsPackagingLabeling/GRAS/NoticeInventory/ucm549588.pdf (accessed on 14 May 2021).
- Madkhali, O.; Mekhail, G.; Wettig, S.D. Modified gelatin nanoparticles for gene delivery. Int. J. Pharm. 2019, 554, 224–234. [Google Scholar] [CrossRef]
- Alipal, J.; MohdPu’ad, N.A.S.; Lee, T.C.; Nayan, N.H.M.; Sahari, N.; Basri, H.; Idris, M.I.; Abdullah, H.Z. A review of gelatin: Properties, sources, process, applications, and commercialisation. Mater. Today Proc. 2021, 42, 240–250. [Google Scholar] [CrossRef]
- Moore, J.N.; Healy, J.R.; Kraft, W.K. Pharmacologic and clinical evaluation of posaconazole. Expert. Rev. Clin. Pharmacol. 2015, 8, 321–334. [Google Scholar] [CrossRef] [PubMed]
- Lipp, H.P. Clinical pharmacodynamics and pharmacokinetics of the antifungal extended-spectrum triazole posaconazole: An overview. Br. J. Clin. Pharmacol. 2010, 4, 471–480. [Google Scholar] [CrossRef] [PubMed] [Green Version]
- Jović, Z.; Janković, S.M.; Ružić Zečević, D.; Milovanović, D.; Stefanović, S.; Folić, M.; Milovanović, J.; Kostić, M. Clinical pharmacokinetics of second-generation triazoles for the treatment of invasive aspergillosis and candidiasis. Eur. J. Drug Metab. Pharmacokinet. 2019, 2, 139–157. [Google Scholar] [CrossRef]
- Lengyel, M.; Kállai-Szabó, N.; Antal, V.; Laki, A.J.; Antal, I. Microparticles, microspheres, and microcapsules for advanced drug delivery. Sci. Pharm. 2019, 87, 20. [Google Scholar] [CrossRef] [Green Version]
- Hens, B.; Bermejo, M.; Tsume, Y.; Gonzalez-Alvarez, I.; Ruan, H.; Matsui, K.; Amidon, G.E.; Cavanagh, K.L.; Kuminek, G.; Benninghoff, G.; et al. Evaluation and optimized selection of supersaturating drug delivery systems of posaconazole (BCS class 2b) in the gastrointestinal simulator (GIS): An in vitro-in silico-in vivo approach. Eur. J. Pharm. Sci. 2018, 115, 258–269. [Google Scholar] [CrossRef]
- Baldino, L.; Cardea, S.; Reverchon, E. Supercritical assisted electrospray: An improved micronization process. Polymers 2019, 11, 244. [Google Scholar] [CrossRef] [Green Version]
- Bhujel, R.; Maharjan, R.; Kim, A.M.; Jeong, S.H. Practical quality attributes of polymeric microparticles with current understanding and future perspectives. J. Drug Del. Sci. Tech. 2021, 64, 102608. [Google Scholar] [CrossRef]
- Owen, D.H.; Katz, D.F. A vaginal fluid simulant. Contraception 1999, 59, 91–95. [Google Scholar] [CrossRef]
- Szekalska, M.; Wróblewska, M.; Trofimiuk, M.; Basa, A.; Winnicka, K. Alginate oligosaccharides affect mechanical properties and antifungal activity of alginate buccal films with posaconazole. Mar. Drugs 2019, 17, 692. [Google Scholar] [CrossRef] [Green Version]
- Komati, S.; Swain, S.; Rao, M.E.B.; Jena, B.R.; Dasi, V. Mucoadhesive multiparticulate drug delivery systems: An extensive review of patents. Adv. Pharm. Bull. 2019, 4, 521–538. [Google Scholar] [CrossRef]
- Costa, P.; Sousa Lobo, J.M. Modeling and comparison of dissolution profiles. Eur. J. Pharm. Sci. 2001, 13, 123–133. [Google Scholar] [CrossRef]
- Cortés, J.C.G.; Curto, M.Á.; Carvalho, V.S.D.; Pérez, P.; Ribas, J.C. The fungal cell wall as a target for the development of new antifungal therapies. Biotechnol. Adv. 2019, 37, 107352. [Google Scholar] [CrossRef] [PubMed]
- Szekalska, M.; Winnicka, K. Evaluation of hard gelatin capsules with alginate microspheres containing model drugs with different water solubility. Acta Pol. Pharm. 2017, 74, 1221–1230. [Google Scholar]
- Sosnik, A.; Seremeta, K.P. Advantages and challenges of the spray-drying technology for the production of pure drug particles and drug-loaded polymeric carriers. Adv. Colloid. Interface Sci. 2015, 223, 40–54. [Google Scholar] [CrossRef]
- Panizzon, G.P.; Bueno, F.G.; Ueda-Nakamura, T.; Nakamura, C.V.; Filho, B.P. Preparation of spray-dried soy isoflavone-loaded gelatin microspheres for enhancement of dissolution: Formulation, characterization and in vitro evaluation. Pharmaceutics 2014, 6, 599–615. [Google Scholar] [CrossRef] [PubMed] [Green Version]
- Salama, A.H. Spray drying as an advantageous strategy for enhancing pharmaceuticals bioavailability. Drug Deliv. Transl. Res. 2020, 10, 1–12. [Google Scholar] [CrossRef]
- Ogunjimi, A.T.; Fiegel, J.; Brogden, N.K. Design and characterization of spray-dried chitosan-naltrexone microspheres for microneedle-assisted transdermal delivery. Pharmaceutics 2020, 12, 496. [Google Scholar] [CrossRef]
- Tejada, G.; Lamas, M.C.; Sortino, M.; Alvarez, V.A.; Leonardi, D. Composite microparticles based on natural mucoadhesive polymers with promising structural properties to protect and improve the antifungal activity of miconazole nitrate. AAPS PharmSciTech 2018, 19, 3712–3722. [Google Scholar] [CrossRef] [PubMed]
- Vehring, R. Pharmaceutical particle engineering via spray drying. Pharm. Res. 2008, 25, 999–1022. [Google Scholar] [CrossRef] [Green Version]
- Pomázi, A.; Buttini, F.; Ambrus, R.; Colombo, P.; Szabó-Révész, P. Effect of polymers for aerolization properties of mannitol-based microcomposites containing meloxicam. Eur. Polym. J. 2013, 49, 2518–2527. [Google Scholar] [CrossRef]
- Agarwal, S.; Aggarwal, S. Mucoadhesive polymeric platform for drug delivery; a comprehensive review. Curr. Drug Deliv. 2015, 12, 139–156. [Google Scholar] [CrossRef] [PubMed]
- Tako, M. Rheological characteristics of fucoidan isolated from commercially cultured Cladosiphon okamuranus. Bot. Mar. 2003, 46, 461–465. [Google Scholar] [CrossRef]
- Yu, S.H.; Wu, S.J.; Wu, J.Y.; Wen, D.Y.; Mi, F.L. Preparation of fucoidan-shelled and genipin-crosslinked chitosan beads for antibacterial application. Carbohydr. Polym. 2015, 126, 97–107. [Google Scholar] [CrossRef]
- Cunha, L.; Grenha, A. Sulfated seaweed polysaccharides as multifunctional materials in drug delivery applications. Mar. Drugs 2016, 14, 42. [Google Scholar] [CrossRef]
- Tran, T.H.; Ramasamy, T.; Poudel, B.K.; Marasini, N.; Moon, B.K.; Cho, H.J.; Choi, H.G.; Yong, C.S.; Kim, J.O. Preparation and characterization of spray-dried gelatin microspheres encapsulating ganciclovir. Macromol. Res. 2014, 22, 124–130. [Google Scholar] [CrossRef]
- Nguyen, V.T.; Ko, S.C.; Oh, G.W.; Heo, S.Y.; Jeon, Y.J.; Park, W.S.; Choi, I.W.; Choi, S.W.; Jung, W.K. Anti-inflammatory effects of sodium alginate/gelatine porous scaffolds merged with fucoidan in murine microglial BV2 cells. Int. J. Biol. Macromol. 2016, 93, 1620–1632. [Google Scholar] [CrossRef]
- Li, Y.; Cao, C.; Pei, Y.; Liu, X.; Tang, K. Preparation and properties of microfibrillated chitin/gelatin composites. Int. J. Biol. Macromol. 2019, 130, 715–719. [Google Scholar] [CrossRef] [PubMed] [Green Version]
- Chatterjee, B.; Amalina, N.; Sengupta, P.; Mandal, U.K. Mucoadhesive polymers and their mode of action: A recent update. J. App. Pharm. Sci. 2017, 7, 195–203. [Google Scholar] [CrossRef] [Green Version]
- van Eyk, A.D.; van der Bijl, P. Porcine vaginal mucosa as an in vitro permeability model for human vaginal mucosa. Int. J. Pharm. 2005, 305, 105–111. [Google Scholar] [CrossRef] [PubMed]
- Sezer, A.D.; Cevher, E.; Hatipoğlu, F.; Oğurtan, Z.; Baş, A.L.; Akbuğa, J. Preparation of fucoidan-chitosan hydrogel and its application as burn healing accelerator on rabbits. Biol. Pharm. Bull. 2008, 31, 2326–2333. [Google Scholar] [CrossRef] [Green Version]
- Bonferoni, M.C.; Chetoni, P.; Giunchedi, P.; Rossi, S.; Ferrari, F.; Burgalassi, S.; Caramella, C. Carrageenan-gelatin mucoadhesive systems for ion-exchange based ophthalmic delivery: In vitro and preliminary in vivo studies. Eur. J. Pharm. Biopharm. 2004, 7, 465–472. [Google Scholar] [CrossRef] [PubMed]
- Li, Z.; He, X. Physiologically based in vitro models to predict the oral dissolution and absorption of a solid drug delivery system. Curr. Drug Metab. 2015, 16, 777–806. [Google Scholar] [CrossRef]
- Chiu, M.H.; Prenner, E.J. Differential scanning calorimetry: An invaluable tool for a detailed thermodynamic characterization of macromolecules and their interactions. J. Pharm. Bioallied Sci. 2011, 3, 39–59. [Google Scholar] [CrossRef]
- Pathak, T.S.; Kim, J.S.; Lee, S.J.; Baek, D.J.; Paeng, K.J. Preparation of alginic acid and metal alginate from algae and their comparative study. J. Polym. Environ. 2008, 16, 198–204. [Google Scholar] [CrossRef]
- Perumal, R.K.; Perumal, S.; Thangam, R.; Gopinath, A.; Ramadass, S.K.; Madhan, B.; Sivasubramanian, S. Collagen-fucoidan blend film with the potential to induce fibroblast proliferation for regenerative applications. Int. J. Biol. Macromol. 2018, 106, 1032–1040. [Google Scholar] [CrossRef] [PubMed]
- Yang, M.; Dong, Z.; Zhang, Y.; Zhang, F.; Wang, Y.; Zhao, Z. Preparation and evaluation of posaconazole-loaded enteric microparticles in rats. Drug Dev. Ind. Pharm. 2017, 43, 618–627. [Google Scholar] [CrossRef] [PubMed]
- DiNunzio, J.C.; Miller, D.A.; Yang, W.; McGinity, J.W.; Williams, R.O. Amorphous compositions using concentration enhancing polymers for improved bioavailability of itraconazole. Mol. Pharm. 2008, 5, 968–980. [Google Scholar] [CrossRef] [PubMed]
- Balouiri, M.; Sadiki, M.; Ibnsouda, S.K. Methods for in vitro evaluating antimicrobial activity: A review. J. Pharm. Anal. 2016, 6, 71–79. [Google Scholar] [CrossRef] [PubMed] [Green Version]
- Oka, S.; Okabe, M.; Tsubura, S.; Mikami, M.; Imai, A. Properties of fucoidans beneficial to oral healthcare. Odontology 2020, 108, 34–42. [Google Scholar] [CrossRef]
- Yamashita, S.; Sugita-Konishi, Y.; Shimizu, M. In vitro bacteriostatic effects of dietary polysaccharides. Food Sci. Technol. Res. 2001, 7, 262–264. [Google Scholar] [CrossRef] [Green Version]
- Amit, C.; Muralikumar, S.; Janaki, S.; Lakshmipathy, M.; Therese, K.L.; Umashankar, V.; Padmanabhan, P.; Narayanan, J. Designing and enhancing the antifungal activity of corneal specific cell penetrating peptide using gelatin hydrogel delivery system. Int. J. Nanomed. 2019, 14, 605–622. [Google Scholar] [CrossRef] [PubMed] [Green Version]
- Tejada, G.; Piccirilli, G.N.; Sortino, M.; Salomón, C.J.; Lamas, M.C.; Leonardi, D. Formulation and in-vitro efficacy of antifungal mucoadhesive polymeric matrices for the delivery of miconazole nitrate. Mater. Sci. Eng. C Mater. Biol. Appl. 2017, 79, 140–150. [Google Scholar] [CrossRef]
- Ammar, H.A.; Rabie, G.H.; Mohamed, E. Novel fabrication of gelatin-encapsulated copper nanoparticles using Aspergillus versicolor and their application in controlling of rotting plant pathogens. Bioprocess Biosyst. Eng. 2019, 42, 1947–1961. [Google Scholar] [CrossRef] [PubMed]

| Formulation | FUC Concentration (%) | GEL Concentration (%) | POS Concentration (%) |
|---|---|---|---|
| F1 | 10 | - | - |
| F2 | 15 | - | - |
| F3 | 20 | - | - |
| F4 | 10 | - | 10 |
| F5 | 15 | - | 10 |
| F6 | 20 | - | 10 |
| GF1 | 10 | 5 | - |
| GF2 | 15 | 5 | - |
| GF3 | 20 | 5 | - |
| GF4 | 10 | 5 | 10 |
| GF5 | 15 | 5 | 10 |
| GF6 | 20 | 5 | 10 |
| Formulation | Percent Loading (%) | Encapsulation Efficiency (%) | Production Yield (%) | Particle Size (µm) | Moisture Content (%) |
|---|---|---|---|---|---|
| F1 | - | - | 67.58 ± 7.37 | 14.89 ± 3.22 | 8.23 ± 4.71 |
| F2 | - | - | 66.88 ± 4.31 | 16.97 ± 4.89 | 6.61 ± 2.99 |
| F3 | - | - | 65.88 ± 4.94 | 17.91 ± 4.35 | 9.81 ± 2.84 |
| F4 | 46.16 ± 0.47 | 92.33 ± 0.94 | 68.89 ± 15.12 | 12.28 ± 6.07 | 8.82 ± 4.17 |
| F5 | 43.80 ± 3.31 | 109.49 ± 9.39 | 63.21 ± 4.61 | 12.02 ± 5.14 | 8.30 ± 4.89 |
| F6 | 34.91 ± 2.84 | 105.83 ± 8.17 | 60.48 ± 3.03 | 13.07 ± 6.57 | 8.07 ± 4.16 |
| GF1 | - | - | 54.04 ± 8.81 | 13.89 ± 4.93 | 6.74 ± 2.12 |
| GF2 | - | - | 47.66 ± 5.79 | 14.46 ± 6.73 | 6.34 ± 1.89 |
| GF3 | - | - | 40.52 ± 3.13 | 16.03 ± 6.72 | 8.23 ± 3.24 |
| GF4 | 46.14 ± 2.32 | 69.17 ± 3.48 | 40.60 ± 6.41 | 12.42 ± 5.58 | 8.42 ± 3.25 |
| GF5 | 40.71 ± 1.65 | 80.19 ± 2.69 | 49.63 ± 8.05 | 13.54 ± 6.02 | 5.19 ± 0.87 |
| GF6 | 30.97 ± 4.64 | 72.90 ± 8.93 | 48.38 ± 8.26 | 14.96 ± 5.39 | 6.88 ± 1.93 |
| Formulation | Zero Order Kinetics | First Order Kinetics | Highuchi Model | Hixson- Crowell Model | Korsmeyer-Peppas Model | ||||||
|---|---|---|---|---|---|---|---|---|---|---|---|
| R2 | K | R2 | K | R2 | K | R2 | K | R2 | K | n | |
| SVF (pH 4.2) | |||||||||||
| F4 | 0.83 | 1.17 | 0.55 | 0.89 | 0.81 | 7.59 | 0.81 | 2.65 | 0.79 | 0.27 | 0.09 |
| F5 | 0.85 | 1.50 | 0.64 | 0.59 | 0.83 | 9.94 | 0.83 | 2.58 | 0.77 | 0.07 | 0.19 |
| F6 | 0.96 | 1.34 | 0.55 | 0.32 | 0.86 | 9.15 | 0.76 | 3.05 | 0.71 | 0.05 | 0.19 |
| GF4 | 0.74 | 3.28 | 0.52 | 0.05 | 0.91 | 21.20 | 0.99 | 0.27 | 0.74 | 0.27 | 0.16 |
| GF5 | 0.71 | 0.39 | 0.50 | 0.06 | 0.88 | 21.96 | 0.99 | 0.26 | 0.72 | 0.27 | 0.18 |
| GF6 | 0.82 | 3.46 | 0.50 | 0.06 | 0.95 | 21.72 | 0.99 | 0.24 | 0.75 | 2.56 | 0.21 |
| 0.1 M HCl (pH 1.2) | |||||||||||
| F4 | 0.80 | 2.91 | 0.98 | 0.09 | 0.94 | 18.41 | 0.94 | 4.25 | 0.77 | 0.24 | 0.19 |
| F5 | 0.81 | 2.89 | 0.99 | 0.08 | 0.98 | 17.73 | 0.97 | 4.36 | 0.84 | 0.23 | 0.19 |
| F6 | 0.85 | 2.32 | 0.95 | 0.05 | 0.96 | 14.37 | 0.92 | 4.29 | 0.82 | 0.21 | 0.16 |
| GF4 | 0.82 | 2.84 | 0.98 | 0.07 | 0.95 | 17.86 | 0.95 | 4.23 | 0.75 | 0.24 | 0.18 |
| GF5 | 0.99 | 3.32 | 0.98 | 0.08 | 0.98 | 18.73 | 0.99 | 4.56 | 0.95 | 0.18 | 0.22 |
| GF6 | 0.99 | 3.50 | 0.97 | 0.09 | 0.96 | 20.15 | 0.99 | 4.66 | 0.92 | 0.16 | 0.28 |
| Formulation | Name of Strain | ||
|---|---|---|---|
| C. albicans | C. parapsilosis | C. krusei | |
| Zone Inhibition (mm) | |||
| Control * | 11.7 ± 1.9 | 40.7 ± 3.4 | 30.8 ± 1.1 |
| DMSO | 1.9 ± 0.8 | 0.0 ± 0.0 | 1.3 ± 0.2 |
| POS/DMSO | 10.5 ± 1.3 | 45.5 ± 2.4 | 33.5 ± 2.9 |
| F1 | 3.7 ± 3.2 | 11.2 ± 0.8 | 6.1 ± 3.6 |
| F2 | 5.8 ± 5.3 | 11.3 ± 2.3 | 9.2 ± 6.2 |
| F3 | 7.1 ± 5.7 | 16.3 ± 1.7 | 13.8 ± 1.5 |
| F4 | 29.3 ± 1.1 | 34.3 ± 1.5 | 29.5 ± 3.6 |
| F5 | 24.3 ± 1.2 | 36.5 ± 2.6 | 25.7 ± 3.0 |
| F6 | 22.2 ± 3.3 | 38.0 ± 1.4 | 24.9 ± 1.8 |
| GF1 | 17.3 ± 3.6 | 31.8 ± 2.1 | 27.6 ± 2.2 |
| GF2 | 18.2 ± 1.1 | 34.8 ± 3.1 | 21.6 ± 1.7 |
| GF3 | 14.2 ± 2.4 | 35.0 ± 1.8 | 22.3 ± 3.2 |
| GF4 | 28.7 ± 2.1 | 43.2 ± 2.5 | 29.5 ± 3.5 |
| GF5 | 27.2 ± 1.0 | 42.6 ± 6.1 | 29.3 ± 4.1 |
| GF6 | 27.2 ± 1.3 | 42.5 ± 3.2 | 27.9 ± 0.9 |
Publisher’s Note: MDPI stays neutral with regard to jurisdictional claims in published maps and institutional affiliations. |
© 2021 by the authors. Licensee MDPI, Basel, Switzerland. This article is an open access article distributed under the terms and conditions of the Creative Commons Attribution (CC BY) license (https://creativecommons.org/licenses/by/4.0/).
Share and Cite
Szekalska, M.; Citkowska, A.; Wróblewska, M.; Winnicka, K. The Impact of Gelatin on the Pharmaceutical Characteristics of Fucoidan Microspheres with Posaconazole. Materials 2021, 14, 4087. https://doi.org/10.3390/ma14154087
Szekalska M, Citkowska A, Wróblewska M, Winnicka K. The Impact of Gelatin on the Pharmaceutical Characteristics of Fucoidan Microspheres with Posaconazole. Materials. 2021; 14(15):4087. https://doi.org/10.3390/ma14154087
Chicago/Turabian StyleSzekalska, Marta, Aleksandra Citkowska, Magdalena Wróblewska, and Katarzyna Winnicka. 2021. "The Impact of Gelatin on the Pharmaceutical Characteristics of Fucoidan Microspheres with Posaconazole" Materials 14, no. 15: 4087. https://doi.org/10.3390/ma14154087
APA StyleSzekalska, M., Citkowska, A., Wróblewska, M., & Winnicka, K. (2021). The Impact of Gelatin on the Pharmaceutical Characteristics of Fucoidan Microspheres with Posaconazole. Materials, 14(15), 4087. https://doi.org/10.3390/ma14154087

